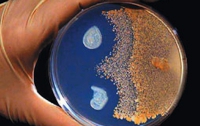
В бостонском метро вот-вот отразят биотеррористическую атаку

ВСЕ НОВОСТИ
-
 18:03 Мир
18:03 Мир
На Бали сейчас лучше не лететь
Полиция Индонезии объявила наивысший уровень готовности к терактам
-
 16:31 Мир
16:31 Мир
Неонацисты Германии готовятся к массовому террору и активно вооружаются
-
 10:50 Мир
10:50 Мир
Как рекламисты «греют руки» на чужой трагедии (ФОТО)
Чудовищная атака на Всемирный торговый центр стала источником дохода для ряда рекламных компаний
-
11:00 Мир
11:00 Мир
В бостонском метро вот-вот отразят биотеррористическую атаку
-
 14:29 Мир
14:29 Мир
Сурово: в Ираке казнили сразу 21 террориста
-
 00:35 Шоу-биз
00:35 Шоу-биз
Как увеличить стоимость однодолларовой купюры? (ФОТО)
Разве что использовать ее как исходный материал для создания оригинальных бумажных фигурок
-
 15:39 Мир
15:39 Мир
«Хезболла» пригрозила Израилю ракетными ударами в случае атак на Иран
На Ближнем Востоке ситуация продолжает быть крайне напряженной
-
 16:45 Мир
16:45 Мир
Ответный удар: сирийские военные убивают оппозиционеров даже за запись в тетради
-
 00:27 Мир
00:27 Мир
Полиция Франции «трясет» журналистов из-за террориста
Жандармы начали спецрасследование из-за публикации переговоров с террористами
-
 13:31 Мир
13:31 Мир
Израильский суд приговорил террориста к 1350 годам тюрьмы
Один из лидеров военизированного крыла ХАМАС получил 54 пожизненных срока
-
 07:21 Наука и техника
07:21 Наука и техника
Пакистан будет использовать Google Maps для охраны границ
Технология позволяет в режиме реального времени отслеживать ситуацию на территории
-
 07:21 Мир
07:21 Мир
В России вводится трехцветная шкала угроз
Владимир Путин подписал Закон «О порядке установления уровней террористической опасности»
-
 11:35 Мир
11:35 Мир
Американцы решили крепче подружиться с мусульманскими странами в ущерб Израилю
-
 05:46 Мир
05:46 Мир
Нигерию продолжают сотрясать теракты на религиозной почве
-
 22:02 Происшествия
22:02 Происшествия
В Днепропетровске пьяный водитель электрокара грозился устроить в городе новые теракты




